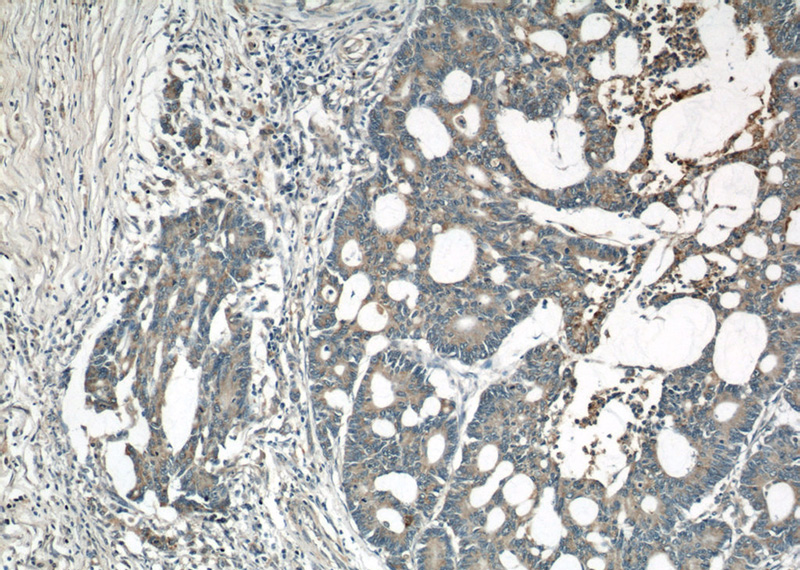
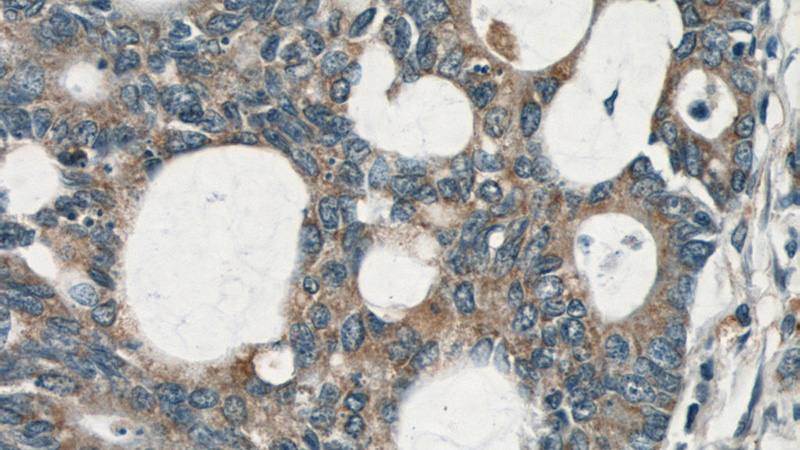

-
Product Name
RHOA antibody
- Documents
-
Description
RHOA Rabbit Polyclonal antibody. Positive WB detected in human brain tissue, HeLa cells, MCF7 cells, mouse brain tissue, rat brain tissue. Positive IHC detected in human colon cancer tissue, human lymphoma tissue. Positive IF detected in HeLa cells. Observed molecular weight by Western-blot: 22 kDa
-
Tested applications
ELISA, WB, IHC, IF
-
Species reactivity
Human, Mouse, Rat; other species not tested.
-
Alternative names
ARH12 antibody; ARHA antibody; h12 antibody; Rho cDNA clone 12 antibody; RHO12 antibody; RHOA antibody; RHOH12 antibody; Transforming protein RhoA antibody
-
Isotype
Rabbit IgG
-
Preparation
This antibody was obtained by immunization of RHOA recombinant protein (Accession Number: NM_001313941). Purification method: Antigen affinity purified.
-
Clonality
Polyclonal
-
Formulation
PBS with 0.1% sodium azide and 50% glycerol pH 7.3.
-
Storage instructions
Store at -20℃. DO NOT ALIQUOT
-
Applications
Recommended Dilution:
WB: 1:200-1:1000
IHC: 1:20-1:200
IF: 1:10-1:100
-
Validations

human brain tissue were subjected to SDS PAGE followed by western blot with Catalog No:114657(RHOA antibody) at dilution of 1:400
Immunohistochemical of paraffin-embedded human colon cancer using Catalog No:114657(RHOA antibody) at dilution of 1:50 (under 10x lens)
Immunohistochemical of paraffin-embedded human colon cancer using Catalog No:114657(RHOA antibody) at dilution of 1:50 (under 40x lens)

Immunofluorescent analysis of HeLa cells using Catalog No:114657(RHOA Antibody) at dilution of 1:25 and Alexa Fluor 488-congugated AffiniPure Goat Anti-Rabbit IgG(H+L)
-
Background
RhoA is a small GTPase protein known to regulate the actin cytoskeleton in the formation of stress fibers. It acts upon two known effector proteins: Rho kinase (RocK) and mdia (Diaphenous protein). RhoA is part of a larger family of related proteins known as the Ras superfamily.
-
References
- Guo H, Lv Y, Tian T. Downregulation of p57 accelerates the growth and invasion of hepatocellular carcinoma. Carcinogenesis. 32(12):1897-904. 2011.
- Liao YC, Ruan JW, Lua I. Overexpressed hPTTG1 promotes breast cancer cell invasion and metastasis by regulating GEF-H1/RhoA signalling. Oncogene. 31(25):3086-97. 2012.
- D'Souza S, Kurihara N, Shiozawa Y. Annexin II interactions with the annexin II receptor enhance multiple myeloma cell adhesion and growth in the bone marrow microenvironment. Blood. 119(8):1888-96. 2012.
- Beck S, Fotinos A, Lang F, Gawaz M, Elvers M. Isoform-specific roles of the GTPase activating protein Nadrin in cytoskeletal reorganization of platelets. Cellular signalling. 25(1):236-46. 2013.
- Ju J, Qi Z, Cai X. Toosendanin induces apoptosis through suppression of JNK signaling pathway in HL-60 cells. Toxicology in vitro : an international journal published in association with BIBRA. 27(1):232-8. 2013.
- Kanazawa Y, Takahashi-Fujigasaki J, Ishizawa S. The Rho-kinase inhibitor fasudil restores normal motor nerve conduction velocity in diabetic rats by assuring the proper localization of adhesion-related molecules in myelinating Schwann cells. Experimental neurology. 247:438-46. 2013.
- Wang J, Sun L, Yang M. DEK depletion negatively regulates Rho/ROCK/MLC pathway in non-small cell lung cancer. The journal of histochemistry and cytochemistry : official journal of the Histochemistry Society. 61(7):510-21. 2013.
- Hu T, Guo H, Wang W. Loss of p57 expression and RhoA overexpression are associated with poor survival of patients with hepatocellular carcinoma. Oncology reports. 30(4):1707-14. 2013.
Related Products / Services
Please note: All products are "FOR RESEARCH USE ONLY AND ARE NOT INTENDED FOR DIAGNOSTIC OR THERAPEUTIC USE"
